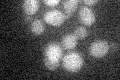
YJL036W
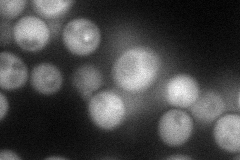
YJL036W
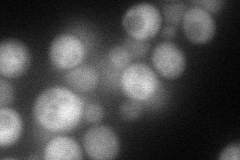
YJL036W
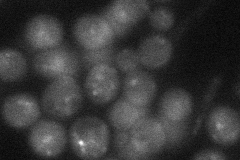
YJL036W
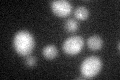
YJL036W

View description
Sorting nexin, involved in retrieval of late-Golgi SNAREs from post-Golgi endosomes to the trans-Golgi network and in cytoplasm to vacuole transport; contains a PX phosphoinositide-binding domain; forms complexes with Snx41p and with Atg20p
Localization:
Intensity:
Fold change:
Significance:
-
C’ GFP library in SD
below threshold14.27 -
N' NOP1pr-GFP in SD
cytosol,punctate65.666 -
N' TEF2pr-mCherry in SD
cytosol,punctate64.3125 -
N' NATIVEpr-GFP in SD
punctate32.5157 -
N' TEF2pr-VC and Cyto-VN in SD

cytosol37.0248 -
C’ GFP library in SD+DTT
cytosol16.551.16No -
C’ GFP library in SD+H2O2

cytosol16.231.13No -
C’ GFP library in Starvation Media

cytosol14.911.04No -
C’ GFP library on the background of Pup2-DaMP

below threshold -
C’ GFP library on the background of CCT mutant

below threshold16.78941.17641No
